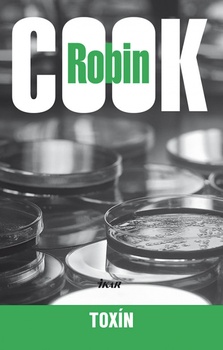
obálka: Toxín, 2. vydanie

Toxín, 2. vydanie (2008)
Autor: Cook Robin
Vydavateľstvo: Ikar
| Bežná cena knihy: | 9,90 € |
|---|---|
| Naša cena: | 9,41 € |
| (zľava 5 %) |
Vypredané
Informácie o knihe
Kim Reggin je srdcový chirurg, uznávaná kapacita vo svojom odbore. Je rozvedený a s bývalou manželkou sa starajú o dcéru Becky, s ktorou ho spája vrúcny cit. Jedného dňa pozve Becky do Onion Ringu (miestny MacDonald) a dcéra si tam objedná nedopečený hamburger. Nakazí sa baktériou E. Coli, ktorá sa do mäsa dostala z chorej kravy. Táto baktéria, rezistentná voči antibiotikám, produkuje nebezpečný toxín. Ten postupne napadne a zničí všetky orgány dievčaťa a nakoniec mu spôsobí smrť. Hlavným vinníkom je mäsospracovateľský priemysel. Kim sa rozhodne zistiť, kto zapríčinil kontamináciu potravín, čím sa dostáva do čoraz väčších problémov. Jeho pátranie sa stáva tŕňom v oku ľuďom, ktorí zarábajú na rýchlom občerstvení obrovské peniaze. Keď sa ocitne v ohrození života, rozhodne sa emigrovať do Švédska a odtiaľ pokračovať v boji.
Zaradené v
Podrobnosti
- ISBN: 978-80-551-1777-5
- Rok vydania: 2008
- EAN: 9788055117775





